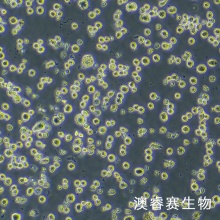
RPMI-8226（人多发性骨髓瘤细胞）

|
一、细胞基本属性
|
|
|
细胞名称
|
RPMI 8226人多发性骨髓瘤外周血B淋巴细胞
|
|
细胞别称
|
骨髓瘤细胞;RPMI 8226; RPMI.8226; RPMI8226; RPMI no 8226; 8226; RPMI 8226/S; RPMI-8226S; RPMI8226/S; 8226/S; Roswell Park Memorial Institute 8226; GM02132; GM2132; GM 2132; Simpson
|
|
商品货号
|
ORC0420
|
|
种属来源
|
人
|
|
年龄性别
|
男,61岁
|
|
组织来源
|
外周血,B淋巴细胞
|
|
生长特性
|
悬浮生长
|
|
细胞形态
|
淋巴细胞样
|
|
背景简介
|
来源于一位61岁的男性浆细胞瘤患者;可产生免疫球蛋白轻链,未检测到重链。
|
|
生物安全等级
|
1
|
|
细胞规格
|
1×106cells/T25培养瓶或者1mL冻存管包装
|
|
支原体检测
|
无
|
|
基因表达情况
|
|
|
保藏机构
|
ATCC; CCL-155 ATCC; CRM-CCL-155 DSMZ; ACC-402 ECACC; 87012702
|
|
培养基
|
80%IMDM+20% FBS+PS
|
|
培养条件
|
气相:95%空气+5%二氧化碳;温度:37℃
|
|
冻存条件
|
无血清冻存液,液氮储存
|
|
倍增时间
|
|
|
STR鉴定位点
|
|
RPMI 8226细胞专用培养基